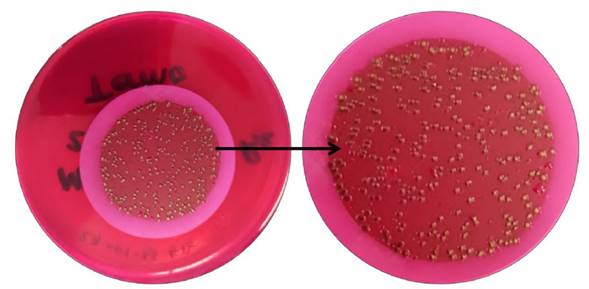

Introducción
El informe mundial de la ONU sobre el desarrollo de los recursos hídricos declara que más de 2,000 millones de personas en el mundo no tienen acceso a los servicios básicos de agua y saneamiento, debido a discriminación de género, creencia religiosa o condición social (ONU, 2019). Esta organización reconoce que el acceso al agua potable y saneamiento es un derecho de la humanidad que debe ser suficiente, salubre y aceptable, considerando a los más vulnerables y marginados (OMS, 2022). Así, el acceso a fuentes de agua con la calidad y disponibilidad adecuada para el abastecimiento humano es un tema de vital importancia tanto para las autoridades como para la sociedad en general (Fernández-Cirelli, 2012), ya que no es reemplazable por otros medios naturales. Es un recurso que abunda en la naturaleza y es la que sustenta toda la vida del planeta Tierra (Fernández-Cirelli, 2012; Pedrozo, 2020). De acuerdo con Cotruvo et al. (2004) el agua para consumo humano se considera un vehículo de excelente diseminación de microorganismos patógenos intestinales, por lo que es necesario el análisis y control de los sistemas de saneamiento de agua de manera periódica con el fin de evaluar sus parámetros y de esta manera, garantizar la calidad para el consumo humano. El agua potable es destinada a múltiples usos domésticos, para la higiene personal, lavado de alimentos y riego de plantas. Por lo tanto, es fundamental garantizar la salud y el bienestar de la población mediante el monitoreo de este tipo de agua, lo que ayuda a disminuir la propagación de enfermedades infecciosas, tanto en los seres humanos como en la fauna (Mora et al., 2012).
La transmisión de enfermedades como el cólera, la disentería, la hepatitis A, la fiebre tifoidea y la poliomielitis están relacionadas con el agua contaminada y el saneamiento. Si los tratamientos para la potabilización son insuficientes o están gestionados de forma inapropiada, la población estará expuesta a riesgos para su salud (OMS, 2022). En México, las enfermedades entéricas son la quinta causa de mortalidad (3.18% de todas las muertes) en niños menores de cinco años. En los estados del centro y norte del país se han realizado estudios de contaminación biológica y química del agua en las tomas de agua domiciliaria y de acuerdo con los resultados se tuvo presencia de coliformes fecales y enterococos fecales (Rodríguez et al., 2020; Olivas et al., 2013). Por otro lado, la contaminación de cuerpos de agua se origina por descargas de desechos domésticos e industriales sin un pretratamiento, así como a la falta de mantenimiento de los sistemas de alcantarillado, que influye de manera importante en la presencia de microorganismos en el agua potable final (Larrea-Murrell et al., 2013; Venegas et al., 2014). Los efectos a la salud de la población están directamente relacionados por el consumo de agua, que no ha sido cuidadosamente monitoreada y que genera alteraciones en las características organolépticas, físicas, químicas y microbiológicas. Es de gran importancia identificar a los agentes microbianos patógenos y no patógenos presentes en el agua para definir posibles indicadores microbiológicos de calidad del agua, que son básicamente organismos que tienen un comportamiento similar a microorganismos patógenos (Ríos-Tobón, 2017). Para determinar la calidad microbiológica del agua se utilizan indicadores bacterianos de contaminación fecal (Alba et al., 2013; Mejía et al., 2021) como Bacillus cereus, Clostridium botulinum y Listeria monocytogenes, Escherichia coli y Salmonella spp (Alba et al., 2013).
En México existe una legislación que regula los sistemas de potabilización del agua para consumo humano, que incluye la determinación de bacterias coliformes totales y E. coli o coliformes fecales, así como la presencia de organismos termotolerantes, en muestras de 100 mL de agua, dichos microorganismos deben estar ausentes en el agua (NOM-127-SSA1-2021; NOM-179-SSA1-2020). En el municipio de Ahome, las fuentes de abastecimiento de agua dulce son contaminadas por la descarga de aguas residuales de forma ilegal, por las excretas de animales a los canales de conducción de agua y por el uso del agua residual para el riego agrícola, provocando contaminación del suelo irrigado que por arrastre alcanza corrientes de agua superficiales, principalmente en épocas de lluvia. Además, al filtrarse existe el riesgo de contaminar acuíferos. Por lo antes mencionado, se consideró importante investigar algunos de los factores asociados a la presencia de patógenos en el municipio de Ahome, como son los legislados por la norma de calidad de agua (NOM-179-SSA-2020), particularmente en la calidad microbiológica del agua para uso doméstico en 15 comunidades rurales en Ahome, Sinaloa. Esto con el fin de identificar y cuantificar la presencia de cloro residual y determinar la presencia de bacterias coliformes fecales termotolerantes como indicadores de la calidad sanitaria del agua.
Materiales y Métodos
El trabajo de investigación se realizó en el municipio de Ahome, al norte del estado de Sinaloa, del cual se seleccionaron 15 localidades rurales de alta vulnerabilidad que presentan una población de entre 400 a 1500 habitantes, donde se obtuvieron muestras de agua de tomas domiciliarias y se evaluó la calidad bacteriológica. Las poblaciones rurales muestreadas fueron Bachomobampo #1 (BA), Bachomobampo # 2 (BC), Flores Magón (FM), Jitzmuri (JI), Guacaporito (GU), Matacahui (MA), El Refugio (EF), Leyva Solano (LS), San Miguel (SM), Choacahui (CH), El Porvenir (EP), Macapul (MC), Bagojo (BG), 18 de marzo (DM) y Las Brisas (LB) (Figura 1).

Figura 1 Ubicación de las poblaciones rurales muestreadas el municipio de Ahome, Sinaloa, Bachomobampo 1 (BA), Bachomobampo 2 (BC), Flores Magón (FM), Jitzmuri (JI), Guacaporito (GU), Matacahui (MA), El Refugio (EF), Leyva Solano (LS), San Miguel (SM), Choacahui (CH), El Porvenir (EP), Macapul (MC), Bagojo (BG), 18 de marzo (DM) y Las Brisas (LB) (Google Earth, 2023).
El período de estudio comprendió de marzo a julio de 2023. Se tomaron por triplicado, 100 mL de muestra de agua para la detección de coliformes fecales y Escherichia coli, la toma de las muestras se realizó en llaves ubicadas en el patio de las viviendas. La boca de la llave se desinfectó con alcohol al 96% y se flameó, se abrió la llave y se dejó correr por 3 minutos, posteriormente las muestras se colocaron en bolsas bacteriológicas estériles marca Nasco® (Figura 2). Una vez colectadas las muestras en las diferentes comunidades, se llevaron al interior de una hielera de poliestireno y se conservaron a una temperatura entre 4 y 8 °C, evitando su contaminación, sin exceder de más de 6 horas su traslado para el análisis, de acuerdo con lo señalado en la NOM-230-SSA1-2002. El procesamiento de las muestras se realizó en las instalaciones de la Universidad Autónoma de Occidente, Unidad Regional Los Mochis. La medición de cloro en las muestras se realizó in situ antes de tomar la muestra de agua, utilizando un Kit de prueba de cloro residual marca Pentair®. Para la determinación del cloro se utilizó una solución de 0.13% de ortotolidina con el 5.14% de ácido clorhídrico. La detección y conteo de bacterias coliformes fecales termotolerantes en las poblaciones estudiadas se realizó mediante un total 45 muestras por triplicado, de acuerdo con lo señalando en la NOM-230-SSA1-2002. En cada comunidad de efectuaron tres muestreos. En todas las muestras se inactivó el cloro residual añadiendo 0.1 mL de tiosulfato de sodio al 3%.

Figura 2 Toma de muestras de agua de la llave en comunidades rurales en el municipio de Ahome, Sinaloa.
En análisis de las muestras se realizó por el método de filtración de membrana para esto, cada muestra de 100 mL se hizo pasar a través de un filtro estéril de membrana de celulosa marca Millipore, con poro 0.45 µm y diámetro de 6 cm, con cuadrícula, utilizando un bomba de vacío (Olivas et al., 2013); la membrana se separó y colocó en una caja de Petri del mismo diámetro, con medio de cultivo Agar Endo (marca Merck®) y se llevaron a incubación a una de temperatura de 44 ºC ± 0.5, durante 24 a 48 horas en una incubadora (Yamato® IC403CR).
Después de la incubación, se identificaron y cuantificaron en un contador de bacterias (Felisa® FE 500), todas las colonias bacterianas de color rojo oscuro con brillo verde metálico, pertenecientes a coliformes fecales termotolerantes (Figura 3). Se registraron los conteos de colonias de bacterias para cada sitio, y se obtuvieron promedios de las tres muestras analizadas para comunidad rural. Los parámetros de referencia para determinar la calidad microbiológica que se utilizaron en esta investigación son lo que establece la Norma Oficial Mexicana NOM-127-SSA1-2021, Agua para uso y consumo humano. Límites permisibles de la calidad del agua.
Resultados
El 80 % de las poblaciones rurales muestreadas y analizadas presentaron resultados positivos para la detección y conteo de coliformes fecales termotolerantes, es decir en 12 de 15 comunidades ejidales, y solo en los poblados de Guacaporito, el Refugio, y el Porvenir se presentaron resultados negativos para la detección de estos microorganismos, lo que se atribuible a que la cloración del agua es más efectiva en estas localidades ya que fue mayor a 1.0 mg L-1. El porcentaje promedio de muestras con resultados positivos para microorganismos termotolerantes variaron de 0 a 89 %, dentro de cada localidad (Figura 4). De las 135 muestras totales analizadas, 104 presentaron un resultado negativo para coliforme fecales termotolerantes y las 31 restantes fueron positivas. Del total de muestras que dieron un resultado positivo, en 24 muestras se pudieron contabilizar entre 1 y 100 UFC 100 mL-1, una con 132 UFC 100 mL-1 y seis fueron incontables. De las 31 muestras positivas a coliformes fecales termotolerantes, 17 no presentaron resultados positivos a la detección para cloro libre residual y en las 14 restantes el cloro libre residual se cuantificó entre 0.1 y 2.0 mg L-1. En las 104 muestras en las que no se identificaron coliformes fecales, se pudo cuantificar el cloro libre residual en 72 de éstas, con valores que oscilaron entre 0.3 y 2.0 mgL-1, en tanto en los 32 restantes no fue detectable.

Figura 4 Porcentaje positividad para coliformes fecales en las poblaciones muestreadas en el municipio de Ahome, Sinaloa, durante marzo-junio 2023. Bachomobampo # 1 (BA), Bachomobampo # 2 (BC), Flores Magón (FM), Jitzmuri (JI), Guacaporito (GU), Matacahui (MA), El Refugio (EF), Leyva Solano (LS), San Miguel (SM), Choacahui (CH), El Porvenir (EP), Macapul (MC), Bagojo (BG), 18 de marzo (DM) y Las Brisas (LB).
Discusión
La presencia de bacterias coliformes fecales termotolerantes en el agua potable en las comunidades rurales en el municipio de Ahome, muestran una alerta por contaminación bacteriológica, sin tener identificado su origen; la variación entre el 11% y el 89% de porcentaje de positividad dentro de las localidades, es evidencia que la contaminación no fue constante en las diferentes fechas de muestreo ni en las diferentes comunidades rurales de Ahome. Sin embargo, se evidenció la existencia de fallas en la dosificación de cloro en los sistemas de potabilización rural, además, falta de mantenimiento de los depósitos de almacenamiento y la red de distribución. La identificación de microorganismos fecales termotolerantes en agua de la llave es una alerta sanitaria que debe ser atendida, para esto es necesario mejorar los controles de calidad del agua potable, para tal efecto es necesario incrementar la vigilancia sanitaria en las redes de distribución de cada comunidad, mejorar la dosificación de la cloración y capacitar de los responsables en los procesos de potabilización municipal.
Es importante continuar estudios sobre la viabilidad de bacterias coliformes y la efectividad del cloro, ya que estos se relacionan con enfermedades entéricas; la legislación mexicana en materia de agua señala que la dosis de cloro residual obligada debe encontrarse entre 0.2 a 1.5 mg L-1 para garantizar la sanidad del agua (NOM-179-SSA1-2020). Sin embargo, la Organización Mundial de la Salud (OMS) menciona que el límite permisible de cloro debe ser de 2 a 3 mg L-1 como mínimo, y un máximo de 5 mg L-1 (WHO, 2022; Fewtrell y Bartram, 2001; Cotruvo et al., 2004). Considerando los niveles de cloro residual de la OMS, en el municipio de Ahome no se cumple con este criterio. Existe el riego latente que la presencia de un patógeno presente en el agua, infecte a la población de una región, reflejando con esto la contaminación del entorno de la misma zona, como puede ser en este caso, por la utilización de aguas residuales en el riego agrícola, excretas de ganado bovino en los canales de conducción de agua, uso de letrina y fosas sépticas en las comunidades estudiadas (Flores et al., 2011).
Conclusiones
En los sistemas de potabilización rural en el municipio de Ahome, Sinaloa la cloración del agua de uso doméstico no es efectiva en la mayor parte de las localidades estudiadas, ya que se detectó que un 80% de las poblaciones presentaron contaminación por coliformes fecales termotolerantes. No fue posible identificar a E. coli en las muestras de agua de la llave de viviendas rurales, sin embargo, si se presentaron resultados positivos para bacterias coliformes fecales termotolerantes, lo cual indica contaminación fecal y poca de efectividad en la cloración que realiza el municipio . Tanto en las muestras de agua que presentaron resultaron positivos, como en las negativas, el cloro residual fue nulo o en cantidades menores a la indicada por la legislación mexicana y OMS. En un futuro la investigación debe incluir el análisis de muestras de agua de las fuentes de abastecimiento como lo son los canales de riego agrícola, para determinar si los patógenos provienen del acuífero o se contaminan durante la red de distribución en cada comunidad.
La realización de estudios adicionales permitirá conocer las fuentes de procedencia de las bacterias identificadas en esta investigación, así también, promover la difusión de los resultados a los diferentes niveles de gobierno, en especial a nivel municipal, para evidenciar la necesidad de desarrollo e implementación de medidas eficientes en los sistemas de potabilización de agua para uso doméstico en poblaciones rurales. También, las dependencias municipales deben asegurarse de que sus sistemas de potabilización cumplen con la normativa de construcción y operación. De esta manera se podrá identificar cualquier fuente de contaminación fecal que pudiera estar afectando los sistemas de saneamiento y facilitar la corrección del problema (NOM-003-CNA-1996; NOM-004-CNA-1996).
Futuras líneas de investigación
Los resultados mostrados en esta investigación evidencian el riesgo de la población a enfermedades entéricas, debido a la contaminación microbiológica por coliformes fecales termotolerantes en el agua potable en comunidades rurales en el municipio de Ahome, Sinaloa. Sin embargo, hubo aspectos importantes que no se incluyeron en esta investigación que constituyen futuras líneas de investigación dentro de este campo del conocimiento. Por lo tanto, es importante continuar con estudios que permitan identificar las posibles fuentes de contaminación de agua, particularmente con las redes de distribución del agua potable en las comunidades y en las fuentes de abastecimiento, como lo son los canales de irrigación agrícola y pozos basado en base a la Norma Oficial Mexicana NOM-179-SSA1-2020. Además, realizar una investigación referente a conocer la capacitación del personal responsable de las plantas potabilizadoras rurales para conocer el nivel de entrenamiento para cumplir esa función. De esta manera, se podrán tomar las medidas correctivas necesarias para que la población pueda disponer de un agua potable que cumpla con los estándares de calidad para su consumo.











 nueva página del texto (beta)
nueva página del texto (beta)